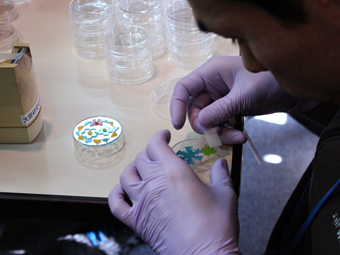
オリジナルペンダントを作っている様子

11月23日(木・祝)に理化学研究所大阪地区で一般公開を開催しました。今年で3回目となる大阪地区での一般公開。「未来の科学を生みだす はじまりは好奇心」をキャッチフレーズに子どもから大人まで楽しめる展示やイベントを多数用意しました。晴天にも恵まれ、昨年の来場者数を大幅に上回る1,215名の来場者が訪れ、大変賑わいました。
今年は昨年に加えて、新たに3つの研究室を公開しました。来場者たちは実験室の中に入り、実験器具を自分の手で触ったり、微生物や動物の細胞を顕微鏡で観察したりしました。また、顕微鏡を開発している研究室では、組み立て真っ最中の最新型レーザー顕微鏡を間近で見ながら、研究者の説明を聴きました。
実験器具や実験動物のイラストに塗り絵をして缶バッジを作るコーナーや、プラズマを使って活性化した材料を貼り合わせ、オリジナルペンダントを作るコーナーは子ども連れのご家族に大人気でした。また、昨年に続き、シビレエイ、透明化ネズミ、光るナノ粒子の展示も大変な人気で、どの展示も行列ができるほど賑わい、研究者達は、休む間もなく、うれしい悲鳴をあげていました。

ミニ講演会として「生命がわかるシミュレーション」をテーマに2つの講演を行いました。来場者からたくさんの質問が出され、関心の高さを物語っていました。また、講演に関連して、実際にスーパーコンピュータを見学してもらいました。メインイベントのひとつ「世界一おもろい授業ライブ」では、柳田敏雄センター長(生命システム研究センター)が研究者の生き方について語りました。満席で立ち見が出るほど混み合いましたが、音楽が流れるリラックスした雰囲気の中で、柳田センター長とファシリテーターを囲むように座った来場者らも徐々に対話に加わりました。研究者としての道を歩み始めた頃の話から、ますます変化する科学技術や社会の中で若い世代はどう生きていったらいいのか、さらに研究者という仕事は儲かるのか儲からないのかという話まで、さまざまな話題についてざっくばらんに語らいました。ライブ終了後も若い来場者達の質問が続きました。
「もっと知ろう!理研の研究」の会場では、113番元素、ポスト京コンピュータ、バイオリソース、再生医療、生体イメージングなどについての展示・説明を行いました。また、「気になるサイエンス」のコーナーではDNA、ゲノム編集、体内時計、腸内細菌など、ニュースやテレビ番組で耳にすることが多いサイエンスの話題を研究者たちがパネルを使って丁寧に説明しました。
